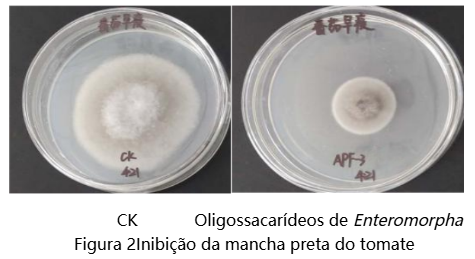

As perdas globais anuais de culturas causadas por doenças chegam a 20%–40%. A dependência excessiva de pesticidas químicos não apenas acelera a resistência dos patógenos, mas também leva à poluição ambiental e riscos para a segurança alimentar. Portanto, o desenvolvimento de indutores de imunidade vegetal verdes e eficazes, bem como fungicidas biobased, tornou-se uma necessidade urgente para a agricultura sustentável.
Como empresa líder no desenvolvimento de substâncias bioativas marinhas, o Grupo Seawin Biotech aproveita seu banco de recursos germinativos de algas verdes controlado de forma independente para quebrar a competição homogênea que há muito tempo restringe os produtos convencionais de oligossacarídeos. Por meio de suas próprias tecnologias patenteadas de hidrólise enzimática direcionada, a empresa foi pioneira em alcançar a produção em larga escala e precisa de oligossacarídeos de algas verdes — em comparação com os oligossacarídeos comumente disponíveis no mercado, os oligossacarídeos de algas verdes exibem atividade biológica distinta na ativação da imunidade vegetal e supressão coordenada de patógenos, graças a suas estruturas de espinha dorsal únicas e diversas, além de modificações naturais de sulfatação.
Esta série de artigos analisará sistematicamente o mecanismo natural de resistência a doenças dos oligossacarídeos de algas verdes e explorará os pontos-chave em sua transição do laboratório para o campo.
Características estruturais dos oligossacarídeos de algas verdes
Os oligossacarídeos de algas verdes são fragmentos moleculares com grau de polimerização (DP) de 2 a 20, obtidos por meio de hidrólise enzimática ou degradação química de polissacarídeos derivados de algas verdes (como Ulva, Enteromorpha e Chaetomorpha).
Suas características estruturais centrais incluem:
· Diversidade de espinha dorsal: Dependendo de sua origem biológica, os oligossacarídeos de algas verdes incluem principalmente α-1,3-ramno-oligossacarídeos (produtos de degradação de polissacarídeos da matriz intercelular de Enteromorpha), β-1,4-mano-oligossacarídeos (derivados de polissacarídeos da parede celular de Chaetomorpha), bem como oligossacarídeos de ligação mista compostos por unidades de ácido glucurônico-xilose-ramnose e xilose-galactose-arabinoze.
· Grupos funcionais ricos: Os oligossacarídeos de algas verdes carregam naturalmente abundantes grupos hidroxila, grupos carboxila (de unidades de ácido urônico) e grupos éster sulfático (como sulfatos de ramno-oligossacarídeos), conferindo-lhes alta hidrofilia e elevada reatividade química.
· Peso molecular controlado com precisão: Por meio do uso de enzimas específicas que clivam ligações glicosídicas e outras tecnologias de hidrólise enzimática direcionada, os polissacarídeos de algas verdes podem ser convertidos de forma direcional em frações de oligossacarídeos bioativos com graus de polimerização definidos.
Os oligossacarídeos de algas verdes exibem atividade dual de resistência a doenças: a combinação sinérgica de ativação de imunidade e ação antimicrobiana direcionada.
1. Atividade indutora de imunidade vegetal
Os oligossacarídeos de algas verdes atuam como padrões moleculares associados a patógenos (PAMPs). São reconhecidos especificamente por receptores de reconhecimento de padrões (PRRs) na membrana celular vegetal, desencadeando assim uma cascata de respostas imunológicas:
(1) Eventos de sinalização precoce
① Estouro de sinalização de íons de cálcio (Ca²⁺)
② Estouro de espécies reativas de oxigênio (ROS)
③ Cascatas de fosforilação de quinases ativadas por mitógenos (MAPK) (como MPK3/MPK6)
(2) Regulação da expressão de genes de defesa
① Via do ácido salicílico (SA): Regula positivamente a expressão de proteínas relacionadas a patógenos PR1 e PR2 (β-1,3-glucanase), induzindo assim resistência adquirida sistêmica (RAS).
② Via do ácido jasmônico (JA) / etileno (ET): Melhora a expressão de genes como inibidores de proteases (PI-II), fortalecendo a resistência contra insetos mastigadores e patógenos necrotróficos.
③ Via metabólica de fenilpropanoides: Promove a atividade de enzimas relacionadas à biossíntese de lignina (como PAL e 4CL), levando ao espessamento da parede celular.
2. Atividade antimicrobiana
Os oligossacarídeos de algas verdes exercem efeitos inibitórios diretos contra uma ampla gama de patógenos vegetais, e sua eficácia antimicrobiana surge de múltiplos mecanismos complementares:
(1) Disrupção física:
Os oligossacarídeos carboxilados carregados negativamente se adsorvem na superfície celular microbiana por meio de interações eletrostáticas, alterando assim a permeabilidade da membrana.
(2) Interferência metabólica:
Os oligossacarídeos sulfatados inibem competitivamente a atividade da quitina sintase fúngica.
(3) Inibição de sinalização de quórum:
Os oligossacarídeos de algas verdes com graus de polimerização e características estruturais específicas podem interferir na transmissão de moléculas de sinalização de patógenos, levando a uma regulação negativa significativa da expressão de fatores de virulência.
Estudo de caso:
Ensaios de confronto em placa mostraram que os oligossacarídeos derivados de Enteromorpha em concentração de 10 mg/mL alcançaram uma taxa de inibição de até 95,7% contra a germinação branca do trigo e até 70,5% contra a mancha preta do tomate.

Os oligossacarídeos de algas verdes, com seus únicos mecanismos duais de resistência a doenças, fornecem uma nova estratégia para a proteção verde de culturas. No entanto, os oligossacarídeos de algas verdes não modificados apresentam inherentemente certas limitações, incluindo estabilidade insuficiente, limiares de atividade elevados e capacidade de direcionamento limitada. Esses desafios tornam essencial a otimização estrutural por meio da engenharia molecular — uma abordagem que será explorada no próximo artigo: "Modificação estrutural e aumento da atividade".
Ao modificar com precisão sítios ativos como grupos hidroxila e carboxila, o Grupo Seawin Biotech está dotando essas moléculas de origem marinha de maior estabilidade, melhor direcionamento e maior eficiência econômica, acelerando sua transição do laboratório para aplicações de campo.
Contexto complementar
Enteromorpha é uma alga macroscópica verde pertencente à família Ulvaceae. É rica em nutrientes benéficos para a saúde humana e há muito tempo é utilizada como recurso de alga comestível no Leste Asiático. Enteromorpha se caracteriza por seu alto teor de proteína e é abundante em fibra dietética, vitaminas e minerais. Mais importante ainda, contém uma gama de compostos bioativos, incluindo polissacarídeos e polifenóis, que estão associados a possíveis benefícios para a saúde, como atividade antioxidante e modulação da imunidade.
Desde o verão de 2008, florações em larga escala de Enteromorpha ocorrem repetidamente no Mar Amarelo e no Mar de Bohai, na China, formando massivas "marés verdes" que representam desafios significativos para os ecossistemas costeiros e as paisagens. Nesse contexto, o Grupo Seawin Biotech, aproveitando as forças científicas da Universidade Oceânica da China, foi pioneiro em estabelecer uma cadeia industrial completa que abrange a coleta profissional offshore, o processamento eficiente onshore e a utilização de alto valor agregado.
Por meio de tecnologias próprias, a empresa converte Enteromorpha da estação de floração em matérias-primas estáveis e de alta qualidade, desenvolvendo-as ainda em aditivos para ração, ingredientes alimentares, insumos agrícolas e produtos biológicos. Essa abordagem permitiu a utilização em larga escala e baseada em recursos de Enteromorpha, convertendo efetivamente um desafio ambiental em valor econômico e ecológico — realizando verdadeiramente o Desenvolvimento Verde e Sustentável.
Stand Nº 22H18 – Até breve no CAC 2026!
Contato:eileen.wang@coub.cn
Tel: 86-532-85901608
Site web: www.seawin-bio.com
Linkedin: https://www.linkedin.com/company/qingdao-seawin-biotech-group
FaceBook: https://www.facebook.com/profile.php?id=100064125487612




